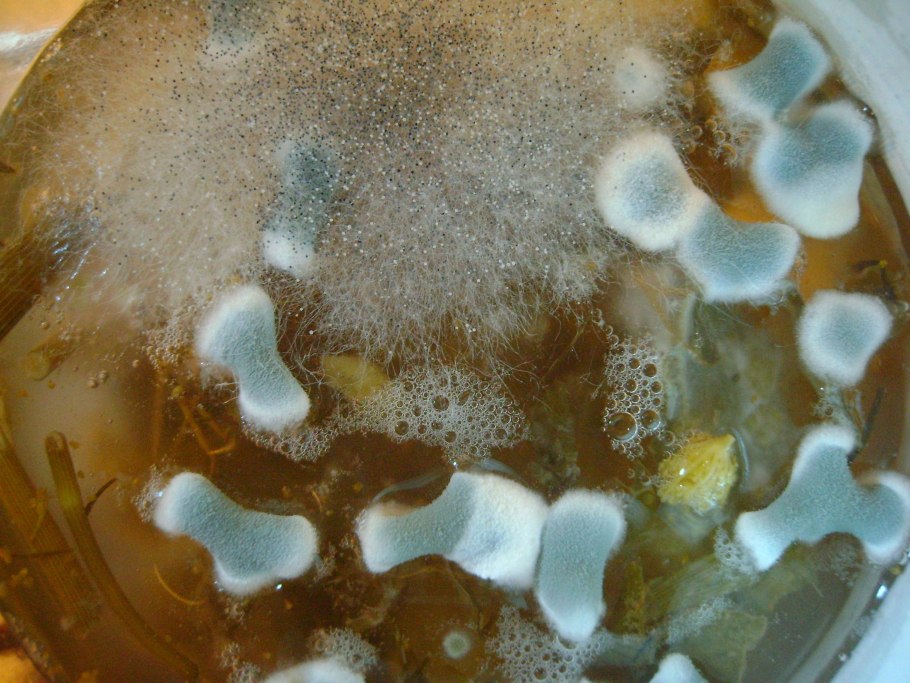

Гриб выделяющий молоко (60 фото)

Млечник лиловеющий

Коричневый гриб с молочком

Скрипица Lactarius vellereus.

Груздь камфорный млечник

Гриб с молоком на срезе

Млечник дубовый Lactarius Quietus

Lactarius volemus

Скрипица Млечный сок

Груздь подмолочник

Подмолочник молочай гриб

Груздь красно-коричневый (Lactarius volemus)

Грибы с белым молочком

Lactarius chrysorrheus

Гриб млечник

Горькушки серушки

Груздь золотисто-желтый (млечник золотистый)

Гриб Вольвариелла слизистоголовая

За грибами

Груздь золотисто-желтый (млечник золотистый)

Груздь белый сырой

Гриб в слизи

Подгруздок дубовый

Рыжик гименофор

Маленькие круглые грибы

Подореховик подорешник гриб

Масленок израильский гриб

Гриб СЛИЗНЯК

Древесные грибы белого цвета

Странные круглые грибы

Подвишенники грибы

Малоизученные виды грибов

Мухомор губчатый

Красивые съедобные грибы

Говорушка листолюбивая

Calvatia utriformis

Корейские грибы Еринги

Гриб гноевик

Гриб навозник зонтик

Копринус гриб навозник

Гриб Евдак

Трутовик овечий гриб

Фомитопсис Пиникола

Морской гриб тремелла

Червивые грибы лисички

Стемонитис слизевик

Млечник блеклый грибы

Gyromitra leucoxantha

Скрипица гриб старый

Маленькие поганки

Мицена молочная

Вешенки альбиносы

Королевский груздь

Плоский коричневый гриб

Спинеллус щетинистый

Съедобные грибы Мурманской области

Весёлка обыкновенная необыкновенно целебный гриб
Phoma плесень

Кувшин для гриба

Грибы на уцзек

Горькушка путик
Поделиться фото в социальных сетях:
Комментариев (0)
Похожие фото:











